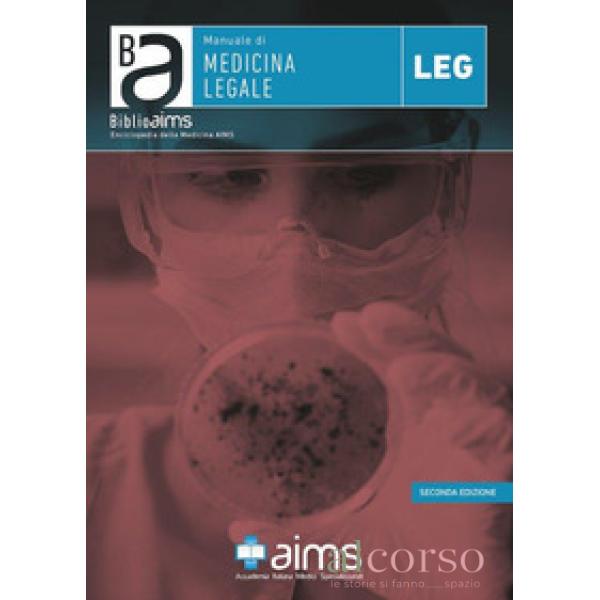

Call us
Free Support: 0438 22725
Medicina legale
Ruolo del medico legale sulla scena del crimine...
Prezzo
27,00 €
Non disponibile
Effetti degli stati di alterazione psico-fisica...
Prezzo
23,00 €
Non disponibile